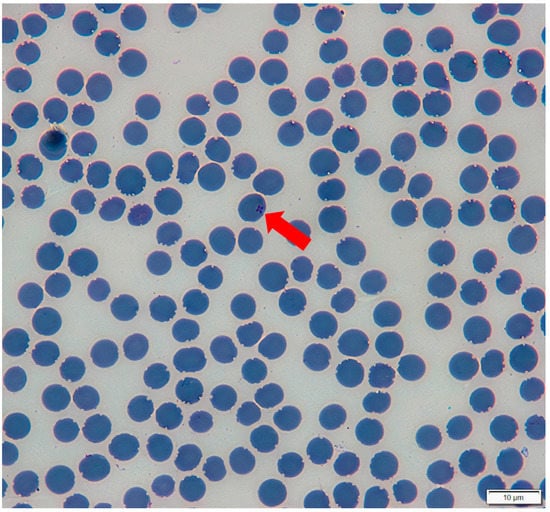

Abstract
The low-land tapir (Tapirus terrestris) is the largest wild terrestrial mammal found in Brazil. Although T. terrestris has been already reported as a host of hemoparasites, the occurrence and genetic identity of Piroplasmida agents in this species is still cloudy. Although it is reported that Theileria equi, an endemic equid-infective agent in Brazil, is occurring in lowland tapirs, these reports are probably misconceived diagnoses since they are solely based on small fragments of 18S rRNA that may not achieve accurate topologies on phylogenetic analyses. The present study aimed to detect and investigate the identity of Theileria spp. in tapirs from Pantanal and Cerrado biomes. Blood-DNA samples from tapirs were screened for a partial (~800 bp) 18S rRNA gene fragment from Piroplasmida and 64 (64/122; 52.46% CI: 43.66–61.11%) presented bands of expected size. Samples were submitted to different protocols for molecular characterization, including near-full length 18S rRNA gene (~1500 bp), and the ema-1 gene from T. equi. Eight sequences were obtained for extended fragments (1182–1473 bp) from the 18S rRNA gene. Moreover, three sequences from partial cox-1 and five from partial hsp70 gene were obtained. None of the samples presented amplifications for the ema-1 gene. Phylogenetic and distance analyses from the 18S rRNA sequences obtained demonstrated a clear separation from tapirs’ Theileria spp. and T. equi. Phylogenetic analyses of cox-1 and hsp70 sequences obtained herein also showed a unique clade formed by tapir’s Theileria spp. Theileria terrestris sp. nov. is positioned apart from all other Theileria species in 18S rRNA, cox-1, and hps70 phylogenetic analyses. This novel proposed species represents a new Piroplasmida clade, yet to be characterized regarding biological features, vectors involved in the transmission cycles, additional vertebrate hosts, and pathogenicity.
1. Introduction
Possibly, a larger number of parasites from Piroplasmida order may occur when compared to the number of vertebrate hosts that are capable of harboring these potential pathogens [1].
The low-land tapir (Tapirus terrestris) is the largest wild terrestrial mammal found in Brazil. Although T. terrestris has already been reported as a host of hemoparasites, such as Trypanosoma sp. [2] and hemoplasmas [3], the occurrence and genetic identity of Piroplasmida agents in this species is still incomplete.
In 2017, the molecular detection of piroplasms was reported in a single tapir from Mato Grosso do Sul State, Midwest Brazil. In this case, partial 18S rRNA (414 bp) amplification followed by sequencing and BLASTn analyses were conducted for nucleotide identity assessment, and BLASTn analysis indicated 98% identity with Theileria equi [4]. A few years later, T. equi was described as occurring in 11 Brazilian low land tapirs from the Amazon biome also based on the amplification of small fragments (392–475 bp) of the 18S rRNA gene and followed by maximum likelihood and Bayesian phylogenetic inferences [5].
The tick Rhipicephalus microplus is often associated as a vector of T. equi among horses in South America. However, due to decisive biological features, such as the fact that this tick species is a one-host tick and the lack of transovarilally transmission of T. equi, the role of R. microplus in T. equi cycle is still obscure [6]. Amblyomma sculptum has been reported infesting T. equi-positive horses in Brazil [7], including horses maintained in the Pantanal wetland areas [8]. However, A. sculptum was not able to transmit T. equi when feeding on infected horses under laboratory conditions [9]. Indeed, A. sculptum has been reported as a frequently found tick species in T. terrestris from Cerrado and Pantanal areas. Rhipicephalus microplus has also been reported in tapirs from these areas, albeit less frequently [10].
The present study aimed to investigate Piroplasmida in tapirs’ blood samples from two Brazilian biomes, namely Cerrado and Pantanal, as well as to describe a new species of Theileria by assessing its phylogenetic positioning using large fragments of the 18S rRNA gene and additional molecular markers.
2. Materials and Methods
2.1. Sampling
Blood samples were collected from tapirs from Cerrado and Pantanal biomes (municipalities of Nova Andradina and Aquiadana, Mato Grosso do Sul State, Brazil). In total, 125 blood samples were collected from 94 living-tapirs: 61 (61/94; 64.89% CI: 54.83–73.78%) from Pantanal wetland areas, 33 (33/94; 35.11% CI: 26.22–45.17%) from Cerrado, and eight road-killed tapirs (8/125; 6.40% CI: 3.28–12.12%), also from Cerrado biome, that were sampled during necropsy procedures, summarizing 102 sampled individuals in both areas [3]. Fast-stained (Romanowsky-type stain) blood smears were made with collected blood samples from living tapirs for investigation of hemoparasites’ inclusions in blood cells by light microscopy (Olympus BX43, Olympus Corporation, Tokyo, Japan) and images were captured using a lens’ attached camera (Olympus DP73, Olympus Corporation, Tokyo, Japan) and computer software (CellSens, Olympus Corporation, Tokyo, Japan).
This study was approved by the Ethics Committee for Animal Experimentation of FCAV/UNESP (Faculty of Agricultural and Veterinary Sciences of the São Paulo State University) under protocol number 4558/20. The “Instituto Chico Mendes de Conservação da Biodiversidade (ICMBIO)” provided the required annual permits for the capture and immobilization of tapirs and collection of biological samples (SISBIO# 14,603). All protocols for the capture, anesthesia, handling, and sampling of tapirs have been reviewed and approved by the Veterinary Advisors of the Association of Zoos and Aquariums (AZA)—Tapir Taxon Advisory Group (TAG), and the Veterinary Committee of the IUCN SSC Tapir Specialist Group (TSG). Further information about study areas and samplings is described elsewhere [3].
2.2. DNA Extraction and PCR Protocols for Mammals’ Endogenous Genes
DNA extraction was performed using a commercial kit (InstaGene™ Matrix, Biorad®, Hercules, CA, USA) and following the manufacturers’ instructions. In order to ensure successful DNA extraction, a conventional PCR for the mammal-endogenous gene glyceraldehyde-3-phosphate dehydrogenase (gapdh) (450 bp fragment) [11] was performed in all samples. Negative samples in the abovementioned PCR protocol were subjected to a second protocol targeting a 227-bp fragment of the irpb interphotoreceptor retinoid-binding protein (irpb) gene [12]. Samples that did not yield amplicons in either of the used PCR protocols were excluded from the subsequent analysis.
2.3. Conventional and Nested PCR Protocols for Piroplasmida Detection and Molecular Characterization
Initially, DNA samples from tapirs’ blood previously positive in the endogenous genes-based PCR protocols were submitted to a screening nested-PCR protocol aiming to amplify a ~800 bp fragment from the 18S rRNA gene of Piroplasmida [13]. Positive samples were then submitted to PCR protocols targeting fragments of different genes (cox-1 [14,15], cox-3 [16,17], hsp70 [18], cytb [16,17], β-tubulin [19], and the intergenic spacer-1/ITS-1 [20]) from Piroplasmida as well as a fragment (396 bp) of ema-1 gene from Theileria equi [21]. Nucleotide sequences of primers and references used for the amplification of these genes are described in Table 1. Samples that yielded strong bands on electrophoresis for the partial 18S rRNA gene were submitted to two additional protocols for amplification of full-length 18S rRNA (~1500 bp) [22,23,24]. All PCR were conducted in a final volume of 25 μL. Detailed reagent concentrations and thermal conditions of all protocols used in the present study can be found in Supplementary File S1.

Table 1.
Conventional and nested PCR protocols used in the present study.
Products obtained in PCR assays were separated by electrophoresis on a 1% agarose gel stained with ethidium bromide (Life Technologies™, Carlsbad, CA, USA) at 100 V/150 mA for 50 min, using 5 μL of amplified DNA per sample. The gels were imaged under ultraviolet light (ChemiDoc MP Imaging System, Bio Rad™, Hercules, CA, USA) using the Image Lab Software v4.1 (Biorad, Hercules, CA, USA). A map was constructed using QGis v. 3.26 software (http://qgis.org accessed on 26 October 2022) to illustrate the results obtained for partial 18S rRNA amplification from individual tapirs from each biome.
2.4. Sequencing, Sequence Analysis and Phylogeny
Amplified products were purified using a commercial kit (Wizard® SV Gel and PCR Clean-Up System, Promega, Madison, WI, USA) and sequenced using the BigDye™ Terminator v3.1 Cycle Sequencing Kit (Thermo Fisher Scientific™, Waltham, MA, USA) and ABI PRISM 310DNA Analyzer (Applied Biosystems™, Foster City, CA, USA) [25], at the “Centro de Recursos Biológicos e Biologia Genômica” (CREBIO, FCAV/UNESP, Jaboticabal, São Paulo, Brazil).
For sequencing of selected amplicons, the same primer pair from each PCR protocol or the primer pair from the 2° reaction of nested PCR assays were used, with exception for sequencing of extended 18S rRNA fragments. In the last case, primers used for sequencing [18,26] are described in Table 2. The obtained sequences were first submitted to a screening test using Geneious 11.1.3 software (http://www.geneious.com (accessed on 21 September 2021)) to evaluate the electropherogram quality and generate the consensus sequences. The BLASTn online program (National Center for Biotechnology Information, Bethesda, MD, USA) [27] was used to analyze the nucleotide sequences aiming to browse and compare with sequences from GenBank international database (http://www.ncbi.nlm.nih.gov/genbank (accessed on 21 September 2021)). Consensus sequences obtained in the current study and those retrieved from GenBank were aligned using the ClustalW software [28] via Bioedit v7.0.5.3 (http://www.mbio.ncsu.edu/BioEdit/bioedit.html, accessed on 3 July 2022) and also improved by an MAFFT alignment performed using GUIDANCE2 online server (http://ww.guidance.tau.ac.il, accessed on 3 August 2022) [29]. Phylogenetic inferences were based on Bayesian analysis via CIPRES online server (https://www.phylo.org/index.php/, accessed on 3 August 2022) [30]. The best-fit model was determined using jModeltest v2.1.6 via CIPRES online server (https://www.phylo.org/index.php/, accessed on 3 August 2022) [31].

Table 2.
Set of primers used for the sequencing of near-full length 18S rRNA gene.
Additionally, a distance-based analysis was performed using SplitsTree v4.14.6 (University of Tubingen, Tubingen, Germany) [32] to investigate the genetic relationship among extended 18S rRNA sequences detected in the present study and those previously deposited in GenBank.
3. Results
3.1. PCR for Endogenous Mammal’s Genes
Out of 125 DNA samples extracted from blood samples, 122 samples (122/125; 97.60% CI: 93.18–99.18%) from 99 individuals successfully amplified the target endogenous genes. Three samples did not present bands of expected size for both protocols and were excluded from further PCR analyses. Regarding the animals that DNA from blood samples was submitted to further analyses; 61 (61/99; 61.62% CI: 51.77–70.59%) were sampled in Pantanal biome, whereas 38 (38/99; 38.38% CI: 29.41–48.23%) were sampled in Cerrado biome.
3.2. Screening Nested PCR for Piroplasmida Partial 18S rRNA Gene (~800 bp)
Out of 122 analyzed samples, 64 (64/122; 52.46% CI: 43.66–61.11%) showed expected band sizes on electrophoresis based on the 18S rRNA gene nested PCR. The 64 positive samples were obtained from 56 animals (56/99; 56.57% CI: 46.74–65.90%). Considering the prevalence at each biome, 41 positive animals were sampled in Pantanal (41/61; 67.21% CI: 54.72–77.66%) and 15 from the Cerrado (15/38; 39.47% CI: 25.60–55.28%). Among positive samples from Cerrado biome, four (4/15; 26.67%; CI: 10.90–51.95%) were collected from road-killed animals. From Pantanal biome, six animals presented more than one positive sample during recaptures in different dates (in duplicates or triplicates), totalizing 48 (48/64; 75% CI: 63.18–83.99%) positive samples from this area. Regarding Cerrado biome, one animal presented more than one positive sample during recaptures in different dates (in duplicate), totalizing 16 (16/64; 25% CI: 16.01–36.82%) positive samples from this area.
The results described above are summarized in Supplementary Files S2 and S3. The map (Figure 1) illustrates the number of tapirs that presented bands of expected sizes for the tested protocol.

Figure 1.
Number of tapirs from each biome that presented blood DNA samples with bands of expected sizes on agarose gel electrophoresis when tested for partial Piroplasmida 18S rRNA gene by nested PCR analysis [13] in Mato Grosso do Sul State. This map was constructed using QGis v. 3.26 software (http://qgis.org, accessed on 26 October 2022).
3.3. Amplification of Molecular Markers for Additional Molecular Characterization of Piroplasmida
Twenty-one samples (21/64; 32.81% CI: 22.57–45.0%) presented fragments of different sizes for the cox-1 protocol and three sequences were successfully obtained. Although the protocol used a ~940 bp target fragment, the cox-1 sequences obtained from tapir ranged from 354 to 410 bp (GenBank access numbers OP169682, OP169600, OP169601). For the amplification of hsp70 gene, 28 (28/64; 43.75%; CI: 32.29–55.91%) samples showed amplification of expected size and five sequences were successfully obtained with sizes ranging from 687 bp to 782 bp (GenBank access numbers (GenBank access numbers OP376711, OP169596-OP169599). Regarding the amplification of the Intragenic Spacer 1 (ITS-1), while 38 samples (38/64; 59.38% CI: 47.15–70.54%) presented amplification for the tested protocol, amplicons showed different size bands. Although different samples were chosen for purification and sequencing attempts, none of them were successfully purified and sequenced.
No sample presented amplification in the PCR protocols targeting the cox-3, cytb, β-tubulin genes, and T. equi ema-1 gene. BLASTn analyses results from the obtained sequences are described in Supplementary File S4.
3.4. Amplification of Extended Sequences from the Piroplasmida 18S rRNA Gene (~1500 bp)
Fifteen samples that presented strong amplification bands on electrophoresis for partial 18S rRNA (~800 bp) were sequenced to confirm identity and submitted to other two PCR protocols targeting an extended sequence of 18S rRNA gene (~1500 bp). Out of 15 samples tested, eight presented bands of the expected size for the first protocol [23,24]. Samples that did not yield bands of the expected size for the first protocol were then submitted to the second protocol [22] and additional four positive samples were obtained. All positive samples for both protocols (n = 12) were sequenced and eight sequences were successfully obtained, presenting sizes ranging from 1182 to 1473 bp (GenBank access numbers (OP023828-OP023835). BLASTn analyses results demonstrated that sequences obtained presented nucleotide identities ranging from 95.23% to 95.53% with Theileria spp. sequences from GenBank (Supplementary File S4).
3.5. Phylogenetic Analyses
For all three molecular markers described below, clades were identified according to the phylogenetic study of Piroplasmida performed by Jalovecka et al. (2019) [33].
The extended 18S rRNA sequences obtained herein were subjected to Bayesian inference phylogeny analysis (Figure 2) with more 65 homologue sequences from GenBank database. Cardiosporidium cionae (GenBank access no. EU052685) was used as an outgroup. A total size of 1460 bp alignment was obtained and TrN+I+G was determined as the best-fit evolutionary model by Bayesian information criteria (BIC), using 107 generations of MCMC (Monte Carlo Markov Chain), two independent runs, and 10% of burn-in. Piroplasmida 18S rRNA sequences obtained from tapirs’ blood samples in the present study formed a clade inside Theileria group, albeit separately from other Theileria species with high post-probability values (100).

Figure 2.
Phylogenetic tree based on the 18S rRNA gene from Piroplasmida. Tree was constructed by Bayesian inference using an alignment size of 1460 bp. Clades (I–X) were identified according to the phylogenetic study of Piroplasmida conducted by Jalovecka et al. (2019). Sequences from the present study are highlighted in green. Post probability values >50 appear in tree. Identifications of the phylogenetic groups as proposed by Jalovecka et al. (2019) are indicated next to taxa or groups.
Regarding phylogenetic analysis based on the cox-1 gene (Figure 3), a Bayesian inference phylogeny was performed with three sequences obtained in the present study and 21 homologous sequences retrieved from GenBank database. Plasmodium falciparum (AAP57966) was used as an external group. The nucleotide sequences were then transformed into amino acids using the ORFINDER software (https://www.ncbi.nlm.nih.gov/orffinder/ (accessed on 10 February 2022)) and a total alignment of 259 amino acids was set up. The analysis was performed using the GTR+G evolutionary model, 107 generations of MCMC with two independent runs, and 10% burn-in. The sequences obtained for this fragment also grouped in a clade separated from other Piroplasmida species clades. The posteriori-probability value between lowland tapirs-associated Theileria and Equus group was 100.

Figure 3.
Phylogenetic tree based on partial cox-1 gene. Tree was constructed by Bayesian inference using an alignment size of 259 amino-acids. A sequence of Plasmodium falciparum (AAP57966) was used as outgroup. Sequences from the present study are highlighted in red. Post probability values >50 appear in tree. Clades (I, III, VII, VIII, IX, X) were identified according to the phylogenetic study of Piroplasmida conducted by Jalovecka et al. (2019) are indicated next to taxa or groups.
Phylogenetic analysis based on the five hsp70 gene fragments obtained herein (Figure 4) was performed by Bayesian inference, with a total alignment of 690 bp, using 17 homologous sequences of the same gene and a sequence of Cryptosporidium ratti (MT507483) as an outgroup. The evolutionary model used for this analysis was F81+G, with 107 generations of MCMC, two independent runs, and 10% burn-in. Sequences from the present study grouped in a separate clade from other Piroplasmida species. This time, the Theileria obtained from lowland tapirs presented as closer related with Theileria sensu stricto and Babesia sensu stricto groups than with Equus group, with a high posteriori-probability value (100).

Figure 4.
Phylogenetic tree based on partial hsp70 gene. Tree was constructed by Bayesian inference using an alignment size of 690 bp. A sequence of Cryptosporidium ratti (MT507483) was used as outgroup. Sequences from the present study are highlighted in bold. Post probability values >50 appear in tree. Clades (I, III, VIII, IX, X) were identified according to the phylogenetic study of Piroplasmida conducted by Jalovecka et al. (2019) are indicated next to taxa or groups.
3.6. Distance Analysis by Splistree Software
A distance analysis was performed with a total alignment of 1460 bp of the Piroplasmida 18S rRNA gene using Splistree with ‘Neighbor-net’ and ‘Uncorrected p-distance’ parameters (Figure 5). Taxons were identified according to the classification proposed by Jalovecka et al. (2019) [33]. Samples from the present study were circled in green. The extended sequences of 18S rRNA obtained herein formed a clearly separated group from T. equi group and other Piroplasmida species.

Figure 5.
Splitstree network based on ‘Neighbor-net’ and ‘Uncorrected-p’ parameters, using an alignment of 1460 bp of the 18S rRNA. Identifications of the phylogenetic groups as proposed by Jalovecka et al. (2019) are indicated next to taxons or groups. Sequences from the present study are circled in green.
3.7. Blood Smears Analysis
Two blood smear samples from PCR-positive tapirs (ID: PO-P and FFO-P-1) presented inclusions suggestive of Piroplasmida infection in erythrocytes. Inclusions showed the classical forms of ‘Maltese cross’ (Figure 6), with the formation of tetrads. The length obtained for the tetrads was 1.42 μm.
Figure 6.
Maltese-Cross inclusions suggestive of Theileria spp. found in erythrocytes of Tapirus terrestris (indicated by the red arrow). Visualization was made by using a light microscope (1000×), during blood smear examination. The animal (ID: PO-P) was positive in a PCR protocol that amplify a fragment of approximately 1500 bp of the 18S rRNA gene from piroplasmids [23,24] in the present study.
3.8. Description of a New Species: Theileria terrestris nov. sp.
DESCRIPTION
Taxonomic review
Theileria terrestris n. sp.
Type-host: Lowland tapir Tapirus terrestris (Mammalia: Peryssodactila).
Type-locality: Pantanal and Cerrado Biomes, Mato Grosso do Sul State, Brazil. (−19.301668883667233, −55.76404347032559; −21.583271686146354, −53.88629288988308).
Type-material: Holotype. A stained thin blood smear from a lowland tapir (T. terrestris–ID: PO-P) from Pantanal biome, containing the holotype (Figure 6) was deposited in the Vector-Borne Bioagents Laboratory of FCAV/UNESP (Jaboticabal, São Paulo, Brazil) in addition to genomic DNA samples extracted from the blood of lowland tapirs. Sample was collected and blood smear was made on 24 August 2018.
Vector: Unknow. It is assumed to be a local species of hard (Ixodida) tick.
Representative sequences: GenBank accession numbers: OP023828-OP0232835 (18S rRNA); OP169682, OP169600 and OP169601 (cox-1); OP376711, OP169596-OP169599 (hsp70).
Etymology: The species is named after it was encountered in Tapirus terrestris hosts from Pantanal and Cerrado Biomes in Brazil.
ZooBank reference numbers: pub: CCF171BB-BE8C-4B98-ABCB-1BAB5E8CFAC7; act: 5674F76B-EA24-46E9-B6CE-ADE9A3819273.
Description: This Theileria organism shows the classical inclusion form inside erythrocytes from T. terrestris, with tetrads of merozoites forming a “Maltese-cross”. It’s location inside the erythrocyte can be described as more peripherical when compared to T. equi inclusions, with a length size found of 1.42 μm. On fast-stained blood smears, it shows a purple-blue coloration. The occurrence of inclusions of different forms or sizes is unknown.
4. Discussion
Analyses conducted herein suggested an evident genetic separation between T. equi and the lowland tapir-related Theileria sp. detected in the present study, based on the near full-length 18S rRNA gene of Piroplasmida. The phylogenetic tree constructed using Bayesian inference and a total alignment size of 1460 bp showed a separation supported by high post probabilities values (100) between Clade VIII (Equus group) and T. terrestris clade. A clear separation was also observed on distance analysis performed using Splitstree software. These findings point out the existence of a potentially new Theileria species/phylogenetic group based on the Piroplasmida topology proposal [33]. The neighbor-joining tree constructed by Jalovecka et al. (2019) [33] with an alignment size of 1638 bp also achieved high bootstrap values (100) on separation of clades belonging to Equus group (Clade VIII), Theileria sensu stricto (Clade IX), and Babesia sensu stricto (Clade X) groups, which were the phylogenetically closest clades in their analysis. In our analysis, Equus group and T. terrestris clades fit more closely related to Cytauxzoon group (Clade VI) and distant from Babesia sensu stricto group. These differences may be due to the different sort of inferences used (neighbor-joining x Bayesian) as well as the fact that we included newly reported genotypes, which may influence the achieved topology. Indeed, Theileria and Cytauxzoon share some biological features. The sporozoites of both these representatives of the Theileriidae family are capable of invading hosts’ leukocytes during the schizogony phase followed by the invasion of red blood cells [1].
Theileria sp. in free-ranging lowland tapirs was reported in post-mortem blood and spleen samples from road-killed animals from the Pantanal biome (Mato Grosso State) [34]. When fragments of approximately 740 bp were analyzed by Bayesian phylogenetic inference, these sequences (GenBank access no. MZ491096, MZ490586) clustered together in a clade with Theileria sp. previously reported in cats from Brazil (GenBank access no. KP410270-KP410273, KF970930) [35,36] and closely related to an T. equi clade [34]. Unfortunately, near-full length 18S rRNA from Theileria genotypes from cats are not available, precluding a better assessment on the phylogenetic positioning of these sequences within Piroplasmida clades. Indeed, 18S rRNA sequences of Theileria sp. obtained from tapirs with approximately 400 bp already fit in a clade separately from T. equi in Bayesian analysis [5], but extended sequences would be significant to highlight the phylogenetic relationship of Theileria sp. obtained from tapirs with those genotypes or species obtained from other wild animals from Brazil.
The equid-associated T. equi is considered endemic in Brazil [8] and a causative of red blood cell destruction [37]. Theileria equi DNA has also been reported in different vertebrate hosts, such as dogs [38], sheep [39] and zebras [40]. Considering its potential capacity to infect a different range of hosts species, sequences retrieved from non-equid hosts that present high percentages of similarity rates on BLASTn analysis may mislead to incorrect taxonomic prediction as T. equi when based solely on this similarity. Previously, occurrence of T. equi was reported in lowland tapirs from Pantanal [4] and Amazon [5] biomes. For both studies, percentages of identity computed by BLASTn analyses were reported as 98% when comparing partial 18S rRNA gene sequences (ranging from 392 to 475 bp) of Theileria spp. from lowland tapirs with homologue sequences from T. equi. Although this value could be considered high, taxonomic positioning based on 18S rRNA partial sequences shows lower accuracy when compared to those performed with (near) complete gene [41], and extended 18S rRNA sequences provide more resolutive phylogenetic positioning of Piroplasmida [17,42,43].
Regarding the other target genes evaluated herein, the topology obtained by the cox-1-based phylogenetic tree was very similar to those obtained with 18S rRNA, with both analyses agreeing when it comes to positioning the T. terrestris-clade closely to, albeit separated from, Clade VIII (post probability value of 94). The use of mitochondrial sequences, as the cox-1 gene fragments, is a useful tool to resolve Piroplasmida phylogenetic topologies [16]. Indeed, some studies performed the concatenated analysis with both 18S rRNA and cox-1 to achieve even more informative topologies [16,44]. Unfortunately, once we are working with clinical samples from wild animals, which were collected in-field, it is difficult to concatenate genes from a single sample in a trustworthy way, once the occurrence of genetic diversity of Theileria members is reported in animals from the same population [45,46,47].
The hsp70 gene from Piroplasmida codifies the heat shock protein 70 proteins. When using fragments from this gene to phylogenetic assess the relationship between T. terrestris-clade and other Piroplasmida clades, we observed that tapirs’ clade is now closely related to Clade IX (Theileria sensu stricto) and Clade X (Babesia sensu stricto) with high post-probabilities values (100). The pattern of evolution of a certain gene is an influent aspect on phylogenetic topologies [48]. Differences in the structure of the hsp70 gene may reflect in distance between taxa once it codifies important functional proteins [49]. Even though the 18S rRNA is considered an important conservative gene for taxonomic positioning of Piroplasmida [33], the use of different nuclear and mitochondrial genes may answer questions about the evolutionary relationship among species from this Order.
Maltese-cross inclusion forms comprise four merozoites in one erythrocyte and are usual during the developmental stages of some Piroplasmida species [50]. This form has been described commonly in Theileria species, such as the horse-related species T. equi, T. haneyi [51], as well as in T. parva and in Theileria sp. from African waterbucks (Kobus defassa) [52]. Besides that, this inclusion form has also been reported for Babesia microti [50,53]. In the present study, Maltese-cross inclusions were found in the blood smear of one infected tapir. The length of the inclusion found in the blood smear of a Theileria-positive tapir from the present study was smaller (1.42 μm) than mean values reported for T. equi (1.88 μm) and larger than mean values of T. haneyi (1.15 μm) [51].
5. Conclusions
Phylogenetic analyses based on near-full length sequences of the 18S rRNA, hsp70, and cox-1 genes supported the description of Theileria terrestris nov. sp. in tapir blood samples, which was positioned apart from all other Theileria species. Theileria terrestris nov. sp. represents a new Piroplasmida clade, yet to be characterized regarding biological features, vectors involved in the transmission cycles, additional vertebrate hosts, and pathogenicity.
Supplementary Materials
The following supporting information can be downloaded at: https://www.mdpi.com/article/10.3390/microorganisms10122319/s1, File S1: Detailed reagent concentrations and thermal conditions of all protocols used in the present study.; File S2: Positive samples for detection of partial 18S rRNA from Piroplasmida: sample identification, biome where the animal was sampled, sampling date, gender and age.; File S3: List of tapirs that were sampled more than once and that presented at least one positive sample for Piroplasmida partial 18S rRNA amplification.; File S4: BLASTn analysis of the obtained gene fragments of Piroplasmida detected in lowland tapirs’ blood samples.
Author Contributions
Conceptualization, A.C.B.M. and M.R.A.; methodology, A.C.B.M., E.P.M., A.d.C.C., A.C.C., L.P., B.C.B.R., J.F.S. and M.R.A.; formal analysis, A.C.B.M. and B.C.B.R.; investigation, A.C.B.M. and M.R.A.; resources, E.P.M., M.R.A. and R.Z.M.; data curation A.C.B.M., J.F.S. and M.R.A.; writing—original draft preparation, A.C.B.M. and M.R.A.; writing—review and editing, J.F.S. and M.R.A.; visualization, M.R.A.; supervision, M.R.A.; project administration, M.R.A.; funding acquisition, E.P.M., M.R.A. and R.Z.M. All authors have read and agreed to the published version of the manuscript.
Funding
This work was supported by FAPESP (Foundation for Research Support of the State of São Paulo: #2019/24403-0; #2020/12037-0) and CNPq (National Council for Scientific and Technological Development; Productivity Grant to Marcos Rogério André [CNPq Process #303701/2021-8]). LTCI’s financial support comes from national and international agencies, including zoological institutions, foundations, private businesses, and private individuals.
Data Availability Statement
GenBank (http://www.ncbi.nlm.nih.gov/genbank) accession numbers: OP023828-OP0232835 (18S rRNA); OP169682, OP169600 and OP169601 (cox-1); OP376711, OP169596-OP169599 (hsp70).
Acknowledgments
This study is part of Anna Mongruel’s thesis. She is carrying out her research at Programa de Pós-Graduação em Medicina Veterinária—Universidade Estadual Júlio de Mesquita Filho (UNESP/Jaboticabal) and is sponsored by a fellowship from Fundação de Apoio à Pesquisa do Estado de São Paulo (FAPESP–Processo número 2019/26403-0) at the the time of this study. Authors would like to thank the Lowland Tapir Conservation Initiative (LTCI)–Instituto de Pesquisas Ecológicas (IPÊ) for kindly providing the biological samples needed for the present study. The study of tapir health has been an important component of the long-term activities of the LTCI-IPÊ in Brazil. The LTCI has the institutional support from the International Union for Conservation of Nature (IUCN) Species Survival Commission (SSC) Tapir Specialist Group (TSG), Association of Zoos and Aquariums (AZA) Tapir Taxon Advisory Group (TAG), and European Association of Zoos and Aquariums (EAZA) Tapir Taxon Advisory Group (TAG).
Conflicts of Interest
The authors declare no conflict of interest.
References
- Schnittger, L.; Ganzinelli, S.; Bhoora, R.; Omondi, D.; Nijhof, A.M.; Florin-Christensen, M. The Piroplasm Babesia, Cytauxzoon, and Theileria in farm and companion animals: Species compilation, molecular phylogeny, and evolutionary inshights. Parasitol. Res. 2022, 121, 1207–1245. [Google Scholar] [CrossRef] [PubMed]
- Acosta, I.C.L.; Costa, A.P.; Nunes, P.H.; Gondim, M.F.N.; Gatti, A.; Rossi, J.L., Jr.; Gennari, S.M.; Marcili, A. Morphological and molecular characterization and phylogenetic relationship of a new species of trypanosome in Tapirus terrestris (lowland tapir), Trypanosoma terrestris sp. nov., from Atlantic Rainforest of southeastern Brazil. Parasit. Vectors 2013, 6, 349. [Google Scholar] [CrossRef] [PubMed]
- Mongruel, A.C.B.; Medici, E.P.; Canena, A.D.C.; Calchi, A.C.; Machado, R.Z.; André, M.R. Expanding the Universe of Hemoplasmas: Multi-Locus Sequencing Reveals Putative Novel Hemoplasmas in Lowland Tapirs (Tapirus terrestris), the Largest Land Mammals in Brazil. Microorganisms 2022, 10, 614. [Google Scholar] [CrossRef]
- Silveira, A.W.; Oliveira, G.G.; Santos, L.M.; Azuaga, L.B.S.; Coutinho, C.R.M.; Echeverria, J.T.; Antunes, T.R.; Ramos, C.A.N.; Souza, A.I. Natural Infection of the South American Tapir (Tapirus terrestris) by Theileria equi. J. Wildl. Dis. 2017, 53, 411–413. [Google Scholar] [CrossRef]
- Gonçalves, T.S.; Barros, F.N.L.; Inoue, L.S.; Farias, D.M.; Lima, J.S.; Nobre, A.V.; Aidar, E.S.A.; Diniz, R.F.R.; Gering, A.P.; Scofield, A. Natural Theileria equi infection in captive Tapirus terrestris (Perissodactyla: Tapiridae) in the Brazilian Amazon. Ticks Tick-Borne Dis. 2020, 11, 101452. [Google Scholar] [CrossRef] [PubMed]
- Scoles, G.A.; Ueti, M.W. Vector Ecology of Equine Piroplasmosis. Annu. Rev. Entomol. 2015, 7, 561–580. [Google Scholar] [CrossRef] [PubMed]
- Santos, T.M.; Roier, E.C.R.; Pires, M.S.; Santos, H.A.; Vilela, J.A.R.; Peckle, M.; Paulino, P.G.; Baldani, C.D.; Massard, C.L. Molecular evidence of Anaplasma phagocytophilum and Theileria equi coinfection in horses from Rio de Janeiro, Brazil. Vet. Anim. Sci. 2019, 20, 100055. [Google Scholar] [CrossRef]
- Campos, J.B.V.; André, M.R.; Gonçalves, L.R.; Freschi, C.R.; Santos, F.M.; Oliveira, C.E.; Piranda, E.M.; Andrade, G.B.; Macedo, G.C.; Machado, R.Z.; et al. Assessment of equine piroplasmids in the Nhecolândia sub-region of Brazilian Pantanal wetland using serological, parasitological, molecular, and hematological approaches. Ticks Tick-Borne Dis. 2019, 10, 714–721. [Google Scholar] [CrossRef]
- Ribeiro, M.F.; da Silveira, J.A.; Bastos, C.V. Failure of the Amblyomma cajennense nymph to become infected by Theileria equi after feeding on acute or chronically infected horses. Exp. Parasitol. 2011, 28, 324–327. [Google Scholar] [CrossRef][Green Version]
- Labruna, M.B.; Martins, T.F.; Acosta, I.C.L.; Serpa, M.C.A.; Soares, H.S.; Teixeira, R.H.F.; Fernandes-Santos, R.C.; Medici, E.P. Ticks and rickettsial exposure in lowland tapirs (Tapirus terrestris) of three Brazilian biomes. Ticks Tick Borne Dis. 2021, 12, 101648. [Google Scholar] [CrossRef] [PubMed]
- Birkenheuer, A.J.; Levy, M.G.; Breitschewerdt, E.B. Development and evaluation of a seminested PCR for detection and differentiation of Babesia gibsoni (Asian genotype) and B. canis DNA in canine blood samples. J. Clin. Microbiol. 2003, 41, 4172–4177. [Google Scholar] [CrossRef] [PubMed]
- Ferreira, E.C.; Contijo, C.M.; Cruz, I.; Melo, M.N.; Silva, A.M. Alternative PCR protocol using a single primer set for assessing DNA quality in several tissues from a large variety of mammalian species living in areas endemic for leishmaniasis. Mem. Inst. Oswaldo Cruz 2010, 105, 895–898. [Google Scholar] [CrossRef] [PubMed]
- Jefferies, R.; Ryan, U.M.; Irwin, P.J. PCR–RFLP for the detection and differentiation of the canine piroplasm species and its use with filter paper-based technologies. Vet. Parasitol. 2007, 144, 20–27. [Google Scholar] [CrossRef] [PubMed]
- Gou, H.; Guan, G.; Liu, A.; Ma, M.; Xu, Z.; Liu, Z.; Ren, Q.; Li, Y.; Yang, J.; Chen, Z.; et al. A DNA barcode for Piroplasmea. Acta Trop. 2012, 124, 92–97. [Google Scholar] [CrossRef] [PubMed]
- Corduneanu, A.; Hrazdilov, K.; Sandor, A.D.; Matei, I.A.; Ionică, A.M.; Barti, L.; Ciocănău, M.A.; Măntoiu, D.S.; Coroiu, I.; Hornok, S.; et al. Babesia vesperuginis, a neglected piroplasmid: New host and geographical records, and phylogenetic relations. Parasit. Vectors 2017, 10, 598–606. [Google Scholar] [CrossRef]
- Schreeg, M.E.; Marr, H.S.; Griffith, E.H.; Tarigo, J.L.; Bird, D.M.; Reichard, M.V.; Birkenheuer, A.J. PCR amplification of a multi-copy mitochondrial gene (cox3) improves detection of Cytauxzoon felis infection as compared to a ribosomal gene (18S). Vet. Parasitol. 2016, 225, 123–130. [Google Scholar] [CrossRef]
- Barbosa, A.D.; Austen, J.; Portas, T.J.; Friend, A.; Ahlstrom, L.A.; Oskam, C.L.; Ryan, U.M.; Irwin, P.J. Sequence analyses at mitochondrial and nuclear loci reveal a novel Theileria sp. and aid in the phylogenetic resolution of piroplasms from Australian marsupials and ticks. PLoS ONE 2019, 4, e0225822. [Google Scholar] [CrossRef]
- Soares, J.F.; Girotto, A.; Brand, P.E.; Da Silva, A.S.; França, R.T.; Lopes, S.T.A.; Labruna, M.B. Detection and molecular characterization of a canine piroplasm from Brazil. Vet. Parasitol. 2011, 180, 203–208. [Google Scholar] [CrossRef]
- Zamoto, A.; Tsuji, M.; Wei, Q.; Cho, S.H.; Shin, E.H.; Kim, T.S.; Leonova, G.N.; Hagiwara, K.; Asakawa, M.; Kariwa, H.; et al. Epizootiologic survey for Babesia microti among small wild mammals in northeastern Eurasia and a geographic diversity in the beta-tubulin gene sequences. J. Vet. Med. Sci. 2004, 66, 785–792. [Google Scholar] [CrossRef]
- Shock, B.C.; Birkenheuer, A.J.; Patton, L.L.; Olfenbuttel, C.; Beringer, J.; Grove, D.M.; Peek, M.; Butfiloski, J.W.; Hughes, D.W.; Lockhart, J.M.; et al. Variation in the ITS-1 and ITS-2 rRNA genomic regions of Cytauxzoon felis from bobcats and pumas in the eastern United States and comparison with sequences from domestic cats. Vet. Parasitol. 2012, 190, 29–35. [Google Scholar] [CrossRef]
- Nicolaiewsky, T.B.; Richter, M.F.; Lunge, V.R.; Cunha, C.W.; Delagostin, O.; Ikuta, N.; Fonseca, A.S.; Da Silva, S.S.; Ozaki, L.S. Detection of Babesia equi (Laveran, 1901) by nested polymerase chain reaction. Vet. Parasitol. 2001, 101, 9–21. [Google Scholar] [CrossRef] [PubMed]
- Kawabuchi, T.; Tsuji, M.; Sado, A.; Matoba, Y.; Asakawa, M.; Ishihara, C. Babesia microti-like parasites detected in feral raccoons (Procyon lotor) captured in Hokkaido, Japan. J. Vet. Med. Sci. 2005, 67, 825–827. [Google Scholar] [CrossRef] [PubMed]
- Oosthuizen, M.C.; Zweygarth, E.; Collins, N.E.; Troskie, M.; Penzhorn, B.L. Identification of a Novel Babesia sp. from a Sable Antelope (Hippotragus niger Harris, 1838). J. Clin. Microbiol. 2008, 46, 2247–2251. [Google Scholar] [CrossRef] [PubMed]
- Greay, T.L.; Zahedi, A.; Krige, A.S.; Owens, J.M.; Rees, R.L.; Ryan, U.M.; Oskam, C.L.; Irwin, P.J. Endemic, exotic and novel apicomplexan parasites detected during a national study of ticks from companion animals in Australia. Parasit. Vectors 2018, 11, 197. [Google Scholar] [CrossRef]
- Sanger, F.; Nicklen, S.; Coulson, A.R. DNA sequencing with chain terminating inhibitors. Proc. Natl. Acad. Sci. USA 1977, 74, 5463–5467. [Google Scholar] [CrossRef]
- Hirata, H.; Kawai, S.; Maeda, M.; Jinnai, M.; Fujisawa, K.; Katakai, Y.; Hikosaka, K.; Tanabe, K.; Yasutomi, Y.; Ishihara, C. Identification and phylogenetic analysis of Japanese Macaque Babesia-1 (JM-1) detected from a Japanese Macaque (Macaca fuscata fuscata). Am. J. Trop. Med. Hyg. 2011, 85, 635–638. [Google Scholar] [CrossRef][Green Version]
- Altschul, S.F.; Gish, W.; Miller, W.; Myers, E.W. Basic local alignment search tool. J. Mol. Biol. 1990, 215, 403–410. [Google Scholar] [CrossRef]
- Hall, T.A. BioEdit: A user-friendly biological sequence alignment editor and analysis program for Windows 95/98/NT. Nucleic Acids Symp. Ser. 1999, 41, 95–98. [Google Scholar]
- Sela, I.; Ashkenazy, H.; Katoh, K.; Pupko, T. GUIDANCE2: Accurate detection of unreliable alignment regions accounting for the uncertainty of multiple parameters. Nucleic Acids Res. 2015, 43, W7–W14. [Google Scholar] [CrossRef]
- Ronquist, F.; Huelsenbeck, J.P. MrBayes 3: Bayesian phylogenetic inference under mixed models. Bioinformatics 2003, 19, 1572–1574. [Google Scholar] [CrossRef]
- Darriba, D.; Taboada, G.L.; Doallo, R.; Posada, D. ModelTest 2: More models, new heuristics and parallel computing. Nat. Methods 2012, 9, 772. [Google Scholar] [CrossRef] [PubMed]
- Huson, D.H.; Bryant, D. Application of phylogenetic networks in evolutionary studies. Mol. Biol. Evol. 2006, 23, 254–267. [Google Scholar] [CrossRef] [PubMed]
- Jalovecka, M.; Sojka, D.; Ascencio, M.; Schinittger, L. Babesia Life Cycle—When Phylogeny Meets Biology. Trends Parasitol. 2019, 35, 365–368. [Google Scholar] [CrossRef] [PubMed]
- Silva, V.L.B.; Almeida, S.L.H.; Maia, M.O.; Santos, T.A.; Pavelegini, L.A.D.; Zaffalon, G.B.; Marcili, A.; Morgado, T.O.; Dutra, V.; Nakazato, L.; et al. Post mortem protozoan hemoparasites detection in wild mammals from Mato Grosso state. Rev. Bras. Parasitol. Vet. 2021, 30, e013021. [Google Scholar] [CrossRef]
- André, M.R.; Baccarim, N.C.D.; Sousa, K.C.M.; Gonçalves, L.R.; Henrique, P.C.; Ontivero, G.R.C.R.; Gonzalez, L.I.H.; Nery, C.C.V.; Chagas, F.C.R.; Monticelli, C.; et al. Arthropod-borne pathogens circulating in free-roaming domestic cats in a zoo environment in Brazil. Ticks Tick Borne Dis. 2014, 5, 545–551. [Google Scholar] [CrossRef] [PubMed]
- André, M.R.; Herrera, H.M.; Fernandes, S.J.; de Sousa, K.C.; Gonçalves, L.R.; Domingos, I.H.; de Macedo, G.C.; Machado, R.Z. Tick-borne agents in domesticated and stray cats from the city of Campo Grande, state of Mato Grosso do Sul, midwestern Brazil. Ticks Tick Borne Dis. 2015, 6, 779–786. [Google Scholar] [CrossRef]
- Bishop, R.P.; Kappmeyer, L.S.; Onzere, C.K.; Odongo, D.O.; Githaka, N.; Sears, K.P.; Knowles, D.P.; Fry, L.M. Equide infective Theileria cluster in distinct 18S rRNA gene clades comprinsing multiple taxa with unusually broad mammalian host ranges. Parasit. Vectors 2020, 13, 2020. [Google Scholar] [CrossRef]
- Inácio, E.L.; Pérez-Macchi, S.; Alabi, A.; Bittencourt, P.; Miller, A. Prevalence and molecular characterization of piroplasmids in domestic dogs from Paraguay. Ticks Tickborne Dis. 2019, 10, 321–327. [Google Scholar] [CrossRef]
- Azmi, K.; Al-Jawabreh, A.; Abdeen, Z. Molecular Detection of Theileria ovis and Theileria equi in Livestock from Palestine. Sci. Rep. 2019, 9, 11557. [Google Scholar] [CrossRef]
- Bhoora, R.V.; Collins, N.E.; Schnittger, L.; Troskie, C.; Marumo, R.; Labuschagne, K.; Smith, R.M.; Dalton, D.L.; Mbizeni, S. Molecular genotyping and epidemiology of equine piroplasmids in South Africa. Ticks Tick Borne Dis. 2020, 11, 101358. [Google Scholar] [CrossRef]
- Wu, S.; Xiong, J.; Yu, Y. Taxonomic resolutions based on 18S rRNA genes: A case study of subclass copepoda. PLoS ONE 2015, 10, e0131498. [Google Scholar] [CrossRef] [PubMed]
- Ikeda, P.; Menezes, T.R.; Torres, J.M.; de Oliveira, C.E.; Lourenço, E.C.; Herrera, H.M.; Machado, R.Z.; André, M.R. First molecular detection of piroplasmids in non-hematophagous bats from Brazil, with evidence of putative novel species. Parasitol. Res. 2021, 120, 301–310. [Google Scholar] [CrossRef] [PubMed]
- Gonçalves, L.R.; Paludo, G.; Bisol, T.B.; Perles, L.; de Oliveira, L.B.; de Oliveira, C.M.; da Silva, T.M.V.; Nantes, W.A.G.; Duarte, M.A.; Santos, F.M.; et al. Molecular detection of piroplasmids in synanthropic rodents, marsupials, and associated ticks from Brazil, with phylogenetic inference of a putative novel Babesia sp. from white-eared opossum (Didelphis albiventris). Parasitol. Res. 2021, 120, 3537–3546. [Google Scholar] [CrossRef] [PubMed]
- Hornok, S.; Corduneanu, A.; Kontschán, J.; Bekő, K.; Szőke, K.; Görföl, T.; Gyuranecz, M.; Sándor, A.D. Analyses of separate and concatenated cox1 and 18S rRNA gene sequences indicate that the bat piroplasm Babesia vesperuginis is phylogenetically close to Cytauxzoon felis and the ‘prototheilerid’ Babesia conradae. Acta Vet. Hung. 2018, 66, 107–115. [Google Scholar] [CrossRef] [PubMed]
- Katzer, F.; Ngugi, D.; Walker, A.R.; McKeever, D.J. Genotypic diversity, a survival strategy for the apicomplexan parasite Theileria parva. Vet. Parasitol. 2010, 167, 236–243. [Google Scholar] [CrossRef]
- Al-Hamidhi, S.; Tageldin, H.M.; Weir, W.; Al-Fahdi, A.; Johnson, E.H.; Bobade, P.; Alqamashoui, B.; Beja-Pereira, A.; Thompson, J.; Kinnaird, J.; et al. Genetic Diversity and Population Structure of Theileria annulata in Oman. PLoS ONE 2015, 10, e0139581. [Google Scholar] [CrossRef]
- Vitari, G.L.V.; Costa, R.L.; Abreu, A.P.M.; Peckle, M.; Silva, C.B.; Paulino, P.G.; Pires, M.S.; Massard, C.L.; Santos, H.A. Genetic Diversity of Theileria equi From Horses in Different Regions of Brazil Based On the 18S rRNA Gene. J. Parasitol. 2019, 105, 186–194. [Google Scholar] [CrossRef]
- Hare, M.P. Prospects for nuclear gene phylogeography. Trends Ecol. Evol. 2001, 16, 700–706. [Google Scholar] [CrossRef]
- Yamasaki, M.; Inokuma, H.; Sugimoto, C.; Shaw, S.E.; Aktas, M.; Yabsley, M.J.; Yamato, O.; Maede, Y. Comparison and phylogenetic analysis of the heat shock protein 70 gene of Babesia parasites from dogs. Vet. Parasitol. 2007, 145, 217–227. [Google Scholar] [CrossRef]
- Yokoyama, N.; Bork, S.; Nishisaka, M.; Hirata, H.; Matsuo, T.; Inoue, N.; Xuan, X.; Suzuki, H.; Sugimoto, C.; Igarashi, I. Roles of the Maltese cross form in the development of parasitemia and protection against Babesia microti infection in mice. Infect. Immun. 2003, 71, 411–417. [Google Scholar] [CrossRef][Green Version]
- Knowles, D.P.; Kappmeyer, L.S.; Haney, D.; Herndon, D.R.; Fry, L.M.; Munro, J.B.; Sears, K.; Ueti, M.W.; Wise, L.N.; Silva, M.; et al. Discovery of a novel species, Theileria haneyi n. sp., infective to equids, highlights exceptional genomic diversity within the genus Theileria: Implications for apicomplexan parasite surveillance. Int. J. Parasitol. 2018, 48, 679–690. [Google Scholar] [CrossRef] [PubMed]
- Fawcett, D.W.; Conrad, P.A.; Grootenhuis, J.G.; Morzaria, S.P. Ultrastructure of the intra-erythrocytic stage of Theileria species from cattle and waterbuck. Tissue Cell 1987, 19, 643–655. [Google Scholar] [CrossRef] [PubMed]
- Camacho, T. Roles of the Maltese Cross Form of Babesia microti in the development of parasitemia in B. microti infection. ASM Infect. Immun. 2004, 72, 4929–4930. [Google Scholar] [CrossRef] [PubMed]
Publisher’s Note: MDPI stays neutral with regard to jurisdictional claims in published maps and institutional affiliations. |
© 2022 by the authors. Licensee MDPI, Basel, Switzerland. This article is an open access article distributed under the terms and conditions of the Creative Commons Attribution (CC BY) license (https://creativecommons.org/licenses/by/4.0/).